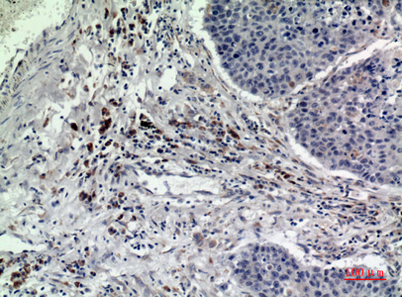

Rab 5A rabbit pAb
 One-click to copy product information
One-click to copy product information$148.00/50µL $248.00/100µL
| 50 µL | $148.00 |
| 100 µL | $248.00 |
Overview
| Product name: | Rab 5A rabbit pAb |
| Reactivity: | Human;Mouse;Rat |
| Alternative Names: | RAB5A; RAB5; Ras-related protein Rab-5A |
| Source: | Rabbit |
| Dilutions: | Western Blot: 1/500 - 1/2000. IHC-p: 1/100-1/300. ELISA: 1/20000. Not yet tested in other applications. |
| Immunogen: | The antiserum was produced against synthesized peptide derived from the Internal region of human RAB5A. AA range:71-120 |
| Storage: | -20°C/1 year |
| Clonality: | Polyclonal |
| Isotype: | IgG |
| Concentration: | 1 mg/ml |
| Observed Band: | 24kD |
| GeneID: | 5868 |
| Human Swiss-Prot No: | P20339 |
| Cellular localization: | Cell membrane ; Lipid-anchor ; Cytoplasmic side . Early endosome membrane ; Lipid-anchor . Melanosome . Cytoplasmic vesicle . Cell projection, ruffle . Membrane . Cytoplasm, cytosol . Cytoplasmic vesicle, phagosome membrane . Endosome membrane . Enriched in stage I melanosomes (PubMed:17081065). Alternates between membrane-bound and cytosolic forms (Probable). . |
| Background: | enzyme regulation:Regulated by guanine nucleotide exchange factors (GEFs) which promote the exchange of bound GDP for free GTP.,function:Required for the fusion of plasma membranes and early endosomes.,similarity:Belongs to the small GTPase superfamily. Rab family.,subcellular location:Enriched in stage I melanosomes.,subunit:Binds EEA1. Interacts with RIN1 and GAPVD1, which regulate its pathway, probably by acting as a GEF. Interacts with ALS2CL, UNC84B, ZFYVE20 and RUFY1. Interacts with SGSM1 and SGSM3., |
-
 Western Blot analysis of HeLa cells using Rab 5A Polyclonal Antibody. Secondary antibody(catalog#:RS0002) was diluted at 1:20000
Western Blot analysis of HeLa cells using Rab 5A Polyclonal Antibody. Secondary antibody(catalog#:RS0002) was diluted at 1:20000 -
Immunohistochemical analysis of paraffin-embedded human-lung, antibody was diluted at 1:100
Immunohistochemical analysis of paraffin-embedded human-lung, antibody was diluted at 1:100 -
 Immunohistochemical analysis of paraffin-embedded human-lung, antibody was diluted at 1:100
Immunohistochemical analysis of paraffin-embedded human-lung, antibody was diluted at 1:100 -
 Western blot analysis of lysate from HeLa cells, using RAB5A Antibody.
Western blot analysis of lysate from HeLa cells, using RAB5A Antibody.

 Manual
Manual